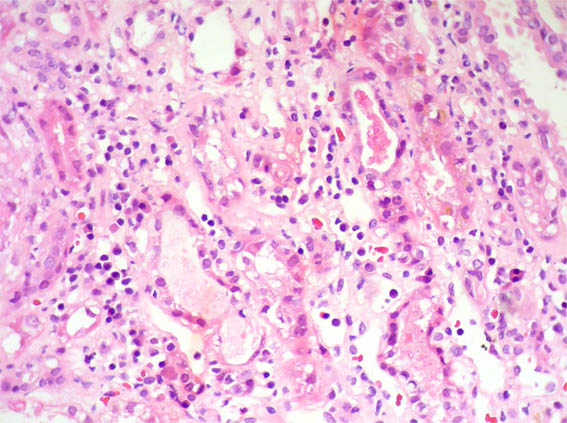

Caso
93 Con discusión |
English
version |
|||
CASO 93 (Noviembre 2013)
Datos clínicos:
Mujer de 63 años de edad con rápido deterioro de su función renal, anuria y malestar general. Ella relata síntomas respiratorios durante los últimos 15 a 20 días. No tenía antecedentes de enfermedad renal, su creatinina sérica fue de 1,0 mg/dL hace un año, cuando fue evaluada por hipertensión. Tiene también historia de dislipidemia. Fumadora de cigarrillo por más de 40 años. Niega consumo regular de algún mmedicamento.
En la exploración física: Paciente alerta y afebril con edema en extremidades inferiores. Presión arterial: 160/95 mmHg, pulso: 84 /min, frecuencia respiratoria: 16 /min. No hay lesiones en piel. En rayos X se evidenciaron opacidades leves en la porción central de ambos pulmones. Ecografía renal reveló leve aumento de tamaño y ecogenicidad de ambos riñones.
Laboratorio: Hb: 10,4 g/dL, plaquetas: 172.000 /μL, creatinina sérica: 8,9 mg/dL, aclaramiento de creatinina: 8 ml/min, BUN: 98 mg/dL. Proteínas séricas: 6,7 g/dL, albúmina: 3,1 g/dL. Análisis de orina: proteínas: 2+, eritrocitos 50-60 /campo de gran aumento (CGA), leucocitos: 10-12 /CGA. Volumen urinario: 250 mL/24h . Pruebas para virus de la hepatitis: negativas, VIH: negativo. ANAs: negativo, C3: 124 mg/dL (90-180), C4: 27 mg/dL (10-40). ANCAs: negativo. Crioglobulinas: negativas. Se inició hemodiálisis.
Se hace biopsia renal. Observe las imágenes.

Figura 1. H&E, X100.

Figura 2. H&E, X400.
Figura 3. H&E, X400.

Figura 4. Tricrómico de Masson, X400.

Figura 5. PAS, X400.

Figura 6. Plata-metenamina, X400.

Figura 7. Plata-metenamina, X400.

Figura 8. Tricrómico de Masson, X400.

Figura 9. Inmunofluorescencia directa para IgG, X400.

Figura 10. Otra imagen de la inmunofluorescencia directa para IgG, X400.

Figura 11. Inmunofluorescencia directa para C3, X400.

Figura 12. Inmunofluorescencia directa para fibrinógeno, X400.
Inmunofluorescencia para IgA, IgM y C1q: Negativas.
¿Cuál es su diagnóstico?